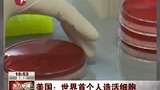
首例人造生命在美国诞生 伦理专家称后果难测-5月22日

-
 01:26
01:26
-
01:07
01:07
-
 00:58
00:58
探秘《钢铁是怎样炼成》的诞生地 战争英雄用生命书写辉煌
时 间:2018-05-08
简 介:世界杯(FIFA World Cup)即国际足联世界杯,是世界上最高荣誉、最高规格、最高水平、最高含金量、最高知名度的足球比赛,与奥运会并称为全球体育两大最顶级赛事,甚至是转播覆盖率超过奥运会的全球体育盛事。 世界杯每四年举办一次,任何国际足联会员国(地区)都可以派出代表队报名参加这项赛事。 巴西目前是夺得该项荣誉最多的球队,共获得5次世界杯冠军,并且在3夺世界杯后永久的保留了前任世界杯雷米特金杯,现在的世界杯是大力神杯。德国在1974年首次捧杯并沿用至今,都统称为世界杯。
-
 00:15
00:15
-
 00:43
00:43
-
 00:14
00:14
-
 00:51
00:51
-
 00:50
00:50
-
 01:08
01:08
-
 00:47
00:47







 换一换
换一换

 全国互联网不良信息举报中心
全国互联网不良信息举报中心 上海市互联网不良信息举报中心
上海市互联网不良信息举报中心 涉枪涉暴恐类违禁内容举报中心
涉枪涉暴恐类违禁内容举报中心 营业执照
营业执照  沪公网安备:31010702008341号
沪公网安备:31010702008341号
